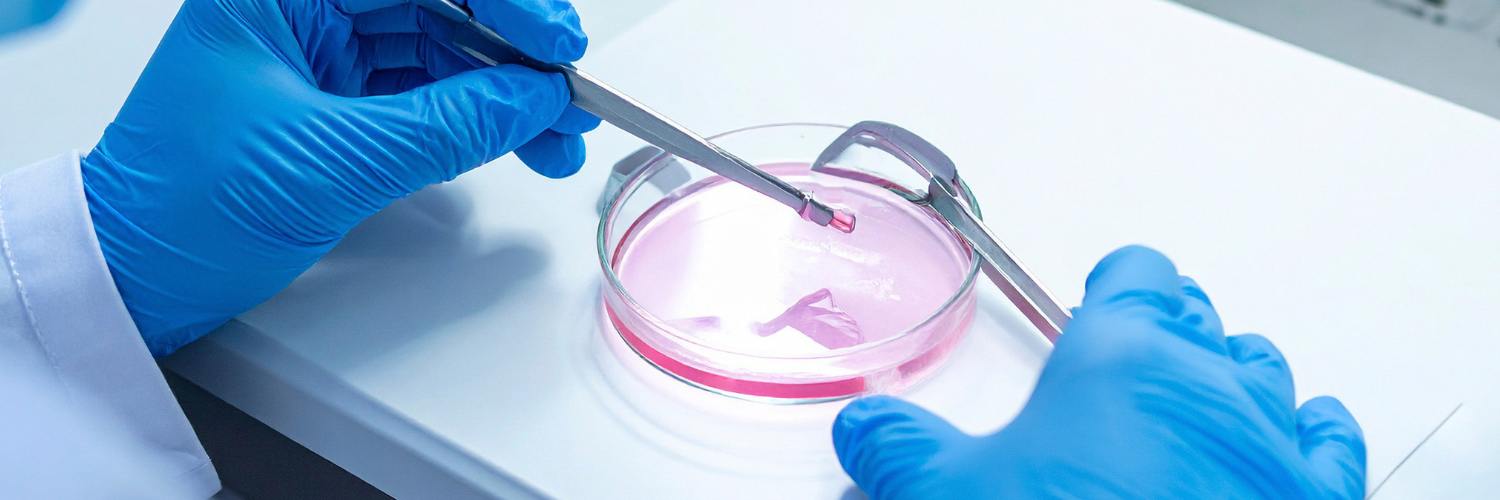

Male Infertility – Often Overlooked but Treatable
Male infertility plays a role in nearly half of all infertility cases, yet it’s often overshadowed in fertility discussions. This blog highlights the common causes, warning signs, and effective treatment options
Read More